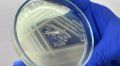
����������� ������� ���������� ����������� � ������� ������� ������ "�����", � ����� �������� �������� ������� � ��������� �������� ����� "����", "����" � "��������� ���������"

Бийчане пожаловались на детей, устроивших погром в их подъезде
Жильцы дома по адресу ул. Красногвардейская, 66 в Бийске пожаловались на компанию из восьми детей примерно от 10 до 14 лет. Так, по словам жительницы дома, дети устроили погром в подъезде, а когда их хотели поймать, они вырвались и «как ни в чм не бывало побежали кучей кататься на новый игровой комплекс».
- Есть сведения, что эти малолетние вандалы из частного сектора, один из них точно учится в 12 школе. Они наведываются к нам уже не в первый раз, от них пострадали уже минимум 3 наших подъезда. В этом году мы поставили новую детскую площадку, боимся, что и её они разнесут»,- говорится в сообщении бийчанки.
Женщина добавила, что жильцы обратились в полицию и ждут результата.
Фото: "ЧП Бийск